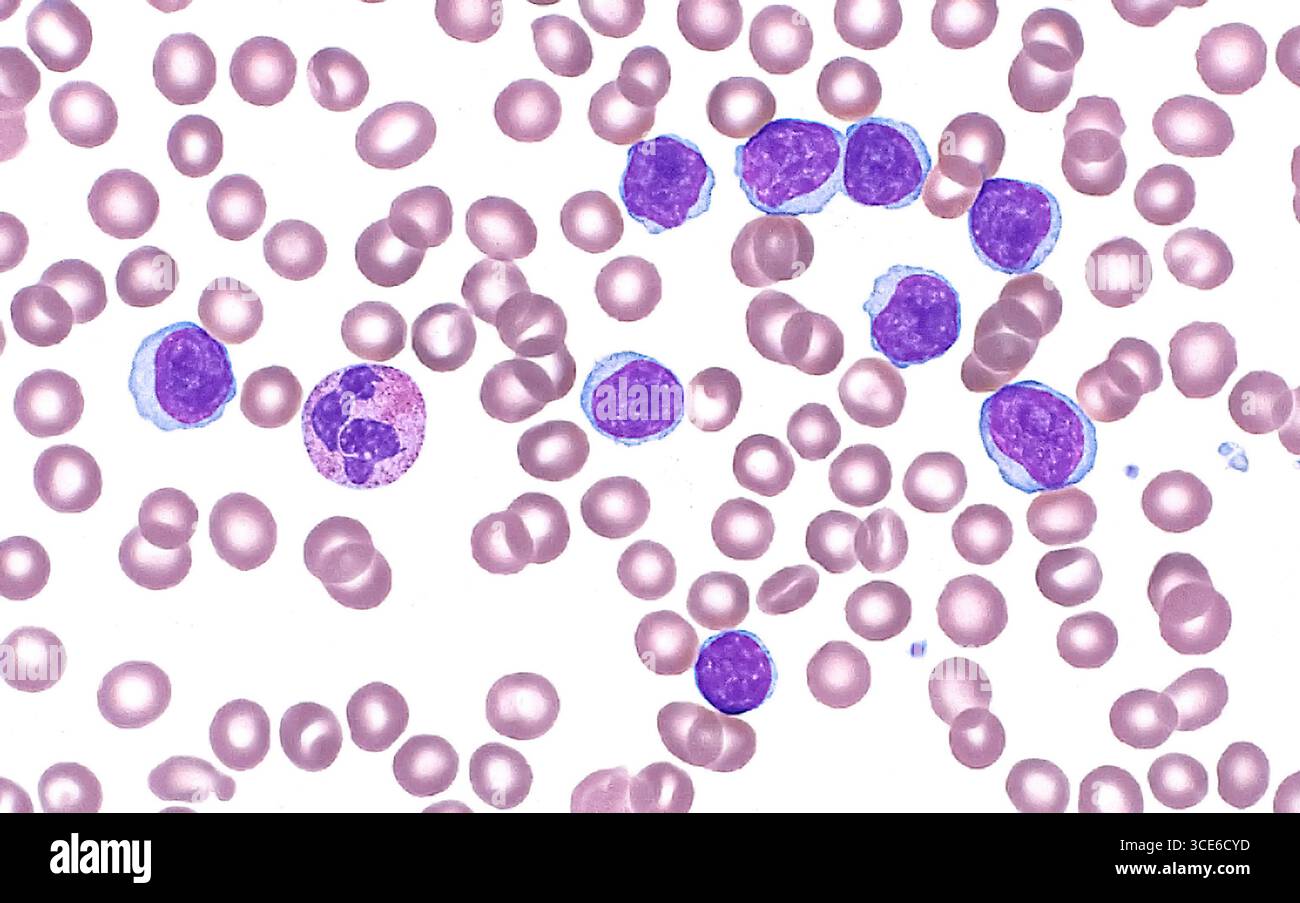
Micrographie légère de la leucémie lymphocytaire de petite taille, qui est un type de cancer du sang. Les cellules leucémiques sont les structures rondes violet foncé et bleu dont neuf sont visibles dans le champ de cette image. Un neutrophile légèrement plus grand est également présent (à droite de la première cellule leucémique à l'extrême gauche de l'image). Plusieurs globules rouges (petits cercles rouges pâles) sont visibles en arrière-plan. Frottis de sang périphérique. Grossissement : 600x lorsqu'il est imprimé à 10cm. Banque D'Images

Micrographie légère de la leucémie lymphocytaire de petite taille, qui est un type de cancer du sang. Les cellules leucémiques sont les structures rondes violet foncé et bleu dont neuf sont visibles dans le champ de cette image. Un neutrophile légèrement plus grand est également présent (à droite de la première cellule leucémique à l'extrême gauche de l'image). Plusieurs globules rouges (petits cercles rouges pâles) sont visibles en arrière-plan. Frottis de sang périphérique. Grossissement : 600x lorsqu'il est imprimé à 10cm.
RFID:ID de l’image:3CE6CYD
Détails de l'image
Contributeur:
Science Photo LibraryID de l’image:
3CE6CYDTaille du fichier:
50,1 MB (870 KB Téléchargement compressé)Autorisations:
Modèle - non | Propriété - nonUne autorisation est-elle nécessaire?Dimensions:
5290 x 3309 px | 44,8 x 28 cm | 17,6 x 11 inches | 300dpiPhotographe:
ZIAD M. EL-ZAATARI/SCIENCE PHOTO LIBRARY